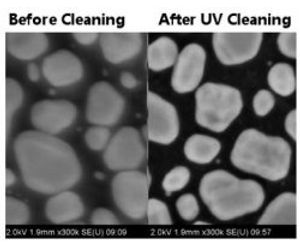

- Home
- Companies
- Shelron Enterprises
- Products
- UV Prep - Ultraviolet System for the ...

UV Prep - Ultraviolet System for the Ultimate Cleaning of SEM Specimens
All SEM sample surfaces are typically coated with a thin hydrocarbon contamination due to sample preparation or storage. This contamination can affect and inhibit good resolution of the sample surface, especially in a FE-SEM. The UV Prep for SEM is the optimal system for the removal of this thin hydrocarbon film without affecting the sample itself.
When stored in an open environment, samples pick up contamination through the air. Unless they are handled carefully, they will also pick up contamination through handling. The UV Prep for SEM is designed to mitigate or eliminate these effects. Why is it so important to remove this contamination prior to examination? Typical FE-SEM users are running at lower and lower beam energies. The lower the beam energy, the more sample surface detail is imaged. That same sample surface that has contaminants on it. If not removed, the user is actually imaging the contaminants, and not the true sample surface.
Many times, when focusing at high magnification in order to perform analysis or capture images at lower magnification, a “black box” can be formed on the sample. In many cases, this is caused by raster burn or electron beam induced deposition (EBID) not of the sample, but of the hydrocarbon contaminants on the sample surface. Removing these hydrocarbons from the surface prior to analysis with the UV Prep for SEM can greatly reduce the appearance of this black box effect.
Many users purchase new FE-SEMs in order to take advantage of their unique operating abilities (high resolution imaging at very low kV). What they don’t realize is that the only way to obtain the advertised resolution of the microscope is to start with a clean sample. Even the best microscopes in the world will give poor images of dirty samples!
Look through our gallery to see how the UV Prep for SEM really can enhance the image quality of a variety of materials under many conditions.
The UV Prep is safe to use on a wide variety of sample materials:
- Metals
- Metal oxides
- Ceramics
- Semiconductors
- Cathode materials for Li batteries
- Polymers
- Carbon nanotubes
- Graphene
- Carbon Fiber
- Anti-reflective Coatings
- Biological samples
The UV Prep uses a customized UV source to effectively attack and break up hydrocarbon bonds. At the same time, reactive species of oxygen react with these hydrocarbon bonds forming molecules such as H2O, CO and CO2, which are pumped out of the chamber. The result is a surface free of hydrocarbon contamination. The built in ozone scrubber also ensures that the ozone generated is not released into the environment.
Easy to use, just load the samples into the system, and set the time and vacuum level for the operation (the UV power is controlled by the vacuum level). Single or multiple samples can be run at the same time, depending on size (although we recommend placing the entire SEM mount holder in the UV Prep for cleaning). A small diaphragm pump is used to obtain the a slight vacuum in the chamber and pump off the reactive species. Typical run-time is 5 to 15 minutes. The UV Prep for SEM can also be used to store samples under vacuum and kept clean for future examination.
- Microprocessor Controlled
- Vacuum Clean/ Storage Modes
- Cleaning Times: 0 to 30 minutes (1 minute steps)
- Vacuum System: Dry Pumping System
- Vacuum Level: Pump down in under 120 seconds
- Dimensions: 360mm x 390mm x 480mm
- Weight: 17 kg
- Input: Single Phase 100 to 240V (50/ 60 Hz)
